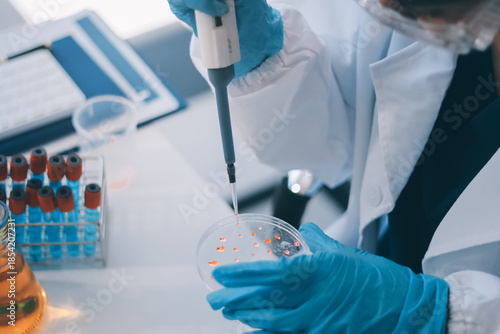

Portrait, science and happy woman on laptop in lab to research chemistry, test or innovation. Microscope, scientist and face of medical doctor in goggles for microbiology, healthcare or pharma study
Contributor: ARMMY PICCA
ID : 1854207231